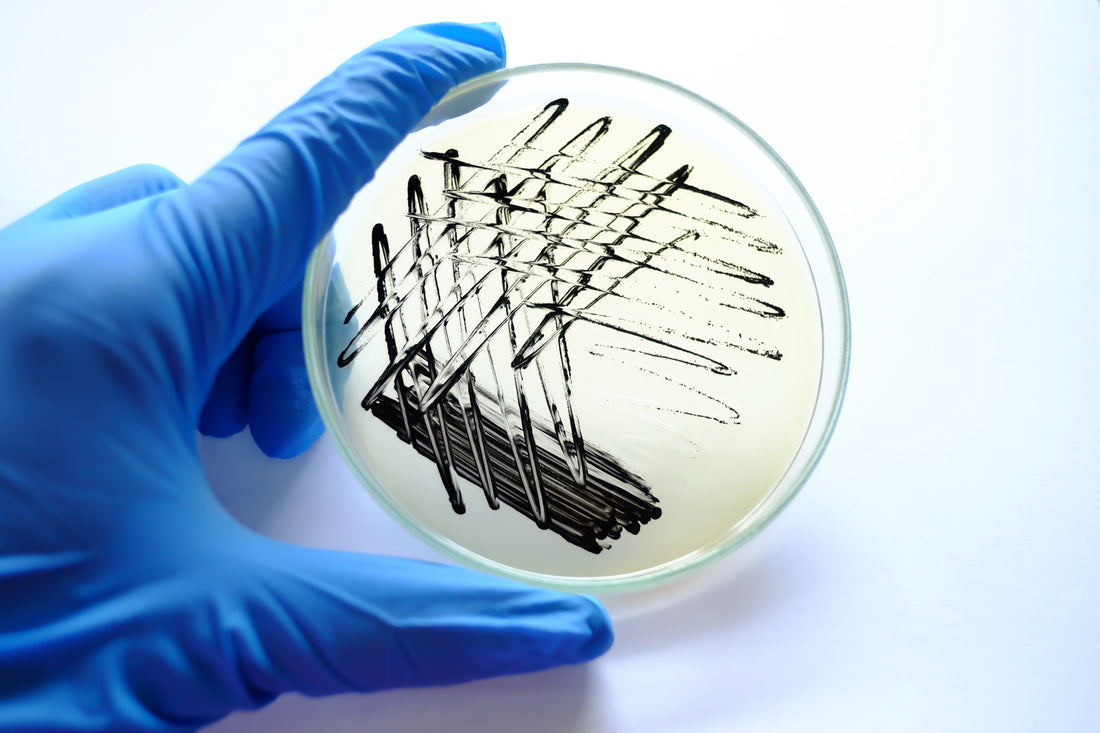

Agar: Types, Production, and Application
As a content and community manager, I leverage my expertise in plant biotechnology, passion for tissue culture, and writing skills to create compelling articles, simplifying intricate scientific concepts, and address your inquiries. As a dedicated science communicator, I strive to spark curiosity and foster a love for science in my audience.


Introduction
Solidifying agents are one of the crucial components of tissue culture media. It offers solid support for the proper growth and development of plants when added to the media. Further, the use of solidifying agents also aids in the uniform distribution of nutrients, hormones, and other essential elements in the culture medium.
The two most common solidifying agents used in the process are agar and gellan gum. Agar is a polysaccharide derived from seaweed. It provides a gel-like consistency to the medium, allowing plant cells to adhere, grow, and differentiate.
Gellan gum is another solidifying agent used in plant tissue culture. Similar to agar, gellan gum is a polysaccharide produced by bacteria, Sphingomonas elodea. It is often utilized as an alternative to agar in plant tissue culture media.
This articles explores on the types, uses, and preparation of agar and how it is applied in plant tissue culture applications.

BASICS OF AGAR
Agar is a solidifying agent and a jelly-like substance used in the preparation of the tissue culture media. Chemically, it’s a gelatinous substance that is extracted from seaweeds. Agar is composed of two components: agarose, and agaropectin. Agarose is a linear polymer of repeating units of agarobiose.
Agarobiose is a disaccharide that consists of D-galactose and 3, 6-anhydro-L-galactopyranose.
Agar is a very useful substance that has its application from food to laboratories. There are many types of agar and all have different applications.
The role of agar in plant tissue culture applications include:
- Solid Support: Agar provides a solid matrix for plant tissue culture media, allowing plants to grow in a structured manner. It provides stability to cultures, preventing them from collapsing.
- Nutrient Absorption: Agar allows the absorption of nutrients and growth regulators by plant tissues. It acts as a carrier of essential nutrients required for plant growth.
- Economic: Agar is relatively inexpensive and widely available, making it a cost-effective choice for solidifying plant tissue culture media.
- pH Stability: Agar maintains a stable pH level in the culture medium, ensuring optimal conditions for plant growth and development.
History and Preparation of Agar
Agar was discovered by Tarazaemon Minoya of Japan in1658. It was the first gelatin product to be introduced as food in the Far East over 300 years ago. Because of its utilization as foodstuff, it was introduced in several other oriental countries. Agar is extracted from the red algae (Rhodophyceae) members Gelidium and Gracilaria. In 1859, the first time, the application of agar was recognized by West people as Chinese foodstuff. In 1982, Robert Koch identified it as an important asset to grow bacteria in the lab. Thus, the manufacturing of bacteriological agar was initiated.
MANUFACTURING OF AGAR
Agar was initially extracted from the Gelidium amansii but created a crisis due to its extensive use. Now, scientists had to search for other sources of agar. This is when Gracilaria seaweed started to be used. However, it was producing a very poor quality agar which couldn’t gel properly. This agar was named agroids. Then Yaganwa introduces the solution for this problem. He transformed the agar obtained from Gracilaria into a strong final product using the alkaline hydrolysis method.
Now, the two techniques available for agar manufacturing include the freezing-thawing method and the Syneresis method. In the freezing and thawing method, the extracted agar from algae is frozen in a freezing tank. Then, they are thawed and strained that makes the agar more concentrated than before. The syneresis method is an advanced and modern technique of manufacturing agar. In this technique, the extracted agar is packed in a cloth with a closed mesh. Then, a horizontal hydraulic pressure is applied to remove water and other impurities from the agar.
The syneresis method is more cost-effective and utilizes lesser energy than the freezing-thawing method. Agar produced by the syneresis technique has higher purity than the one produced by the freezing-thawing method. The dry weight extract obtained after pressing is generally 20% in the syneresis method and 11% in the freezing-thawing method.
Given below is a list of typical gel temperatures extracted from different agarophytes.
| S. No. | Algae | Temperature |
| 1 | Gelidiella | 42-45℃ |
| 2 | Gracilaria | 40-42℃ |
| 3 | Gelidium | 36-38℃ |
| 4 | Pterocladia | 33-35℃ |

Types of agar
Different algae produce different kinds of agar. Each agar has distinct characteristics that satisfy different applications. The agar is solidified because of its agarose content. Agarose has the potential ability to melt when heated and solidify when cooled. Because of this characteristic, they are termes “physical gels”. Polyacrylamide polymerization is an irreversible process and they are termed chemical gels.
Given below is a list of different types of agar that support the different strains of bacterial growth.
| S. No. | Type of Agar | Bacterial studies |
| 1 | Blood agar | Support growth of most bacteria |
| 2 | Luria Bertani (LB) agar | Used for routine cultivation of fastidious microorganisms and serve as a general medium for microbiological studies |
| 3 | Chocolate agar | Support growth of Haemophilus species and Neisseria |
| 4 | MacConkey agar | Supports the growth of gram-negative bacteria |
| 5 | Nutrient agar | To grow different type of bacteria (not all) and some fungi |
| 6 | Neomycin agar | To culture microorganisms anaerobically |
Other than these, the tissue culture grade agar is used for the growth of plants and other biotechnological purposes in research labs and by culturists.
Applications of Agar
- In food preparations: Agar is used as a food additive as it contains a high amount of soluble dietary fibers. It has a higher capacity of water retention, degradable by microbes present in the colon, and don’t produce flatulence as it doesn’t ferment.
- In the preparation of food for insects: It is used to feed larval phases of fruit flies that are used for genetic research. They are also used for breeding insects and other smaller animal species.
- For plant tissue culture: Agar is used as a solidifying agent in plant growth media. They support the proper growth of cultures and the development of roots.
- In the preparation of culture media for microorganisms: In the above table, you have learned various types of bacteriological agar. This agar is prepared from different algae and mixed with other nutrients that support the growth of different types of microbes.
- As gels for denture molding
- For the production of archaeological remains
- For the reproduction of fingerprinting in police work
Need High-Quality Plant Tissue Culture Reagents For Your Tissue Culture Applications? Plant Cell Technology Is Your Partner!
Plant Cell Technology is helping tissue culturists worldwide by providing unique and world-class products and services that smoothen their process. The PCT Store has MS media, agar, gellan gum, Plant Preservative Mixture (PPM™), culture vessels, Biocoupler™, and masks in its store to facilitate your processes.
And, that’s not it! Plant Cell Technology also offers consultation services to culturists of all sizes that help to get instant solutions to your tissue culture problems.
You can either book a one-on-one consultation call or a physical visit to your lab. We help you at every step of the tissue culture process, ranging from establishing a tissue culture lab to preventing contamination problems or any specific challenges in your process.
Further, in the coming month, we are conducting a range of Master Classes for tissue culture enthusiasts like you. The class offers you the great opportunity to directly learn from the experts in the area, who have 10-30+ years of experience.
So, visit plantcelltechnology.com today and learn more about our products and services and how they help you excel in your tissue culture processes.
Happy Culturing!
References
- Armisén, R., & Gaiatas, F. (2009). Agar. Handbook of Hydrocolloids, 82–107. doi:10.1533/9781845695873.82
- https://www.sciencebuddies.org/science-fair-projects/references/grow-microbes-agar
- https://www.britannica.com/topic/agar-seaweed-product
- https://study.com/academy/lesson/what-is-agar.html
Blog Categories
View by Level
Popular Blogs

How Tissue Culture Supports Vertical Farming and Urban Agriculture?
Introduction If you've ever seen a large-scale vertical farm, with its towering racks of perfect, vibrant greens, you might wonder...
Read More
How Bioreactors Are Revolutionizing Large-Scale Micropropagation?
Introduction Have you ever wondered what the secret is to producing thousands, or even hundreds of thousands, of identical, healthy...
Read MoreSubscribe to Our Newsletter










Join the conversation
Your email address will not be published. Required fields are marked